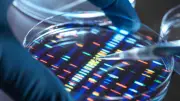
25 Jahre nach dem Genom-Durchbruch: Warum die Genetik noch viele Rätsel birgt

Genetik: 25 Jahre nach dem Durchbruch bleiben Fragen offen
Die Entschlüsselung des menschlichen Genoms vor 25 Jahren revolutionierte die Medizin, doch viele Fragen zu Krebs, Alzheimer und der Genregulation sind unbeantwortet. Neue Technologien wie KI und Genschere eröffnen Chancen, werfen aber ethische Fragen auf